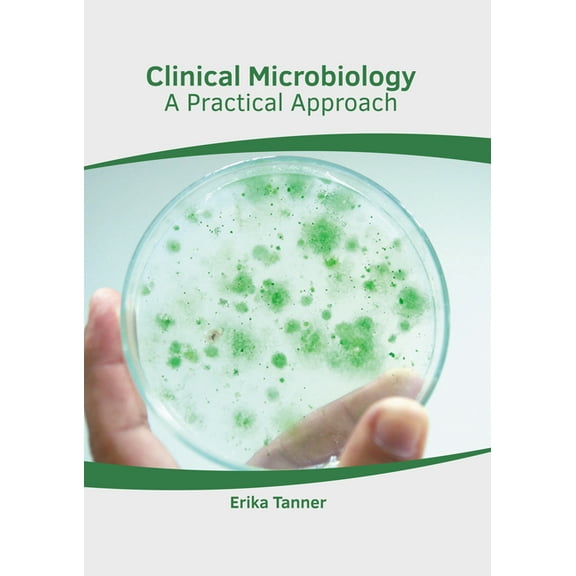
Clinical Microbiology: A Practical Approach, (Hardcover)

Dominans Og Erotisk Underkastelse Underdanig Fotograf, Book 2, (Paperback)
(No ratings yet)
Current price is USD$8.99
Price when purchased online
- Free 90-day returns
How do you want your item?
Try 30 days of Free Shipping with Walmart+! Choose plan at checkout.
Columbus, 43215
Arrives by Tue, Feb 10
Sold and shipped by Walmart.com
Free 90-day returns
This item is gift eligible
More seller options (1)
Starting from $10.28
About this item
Customer ratings & reviews
0 ratings|0 reviews
This item does not have any reviews yet